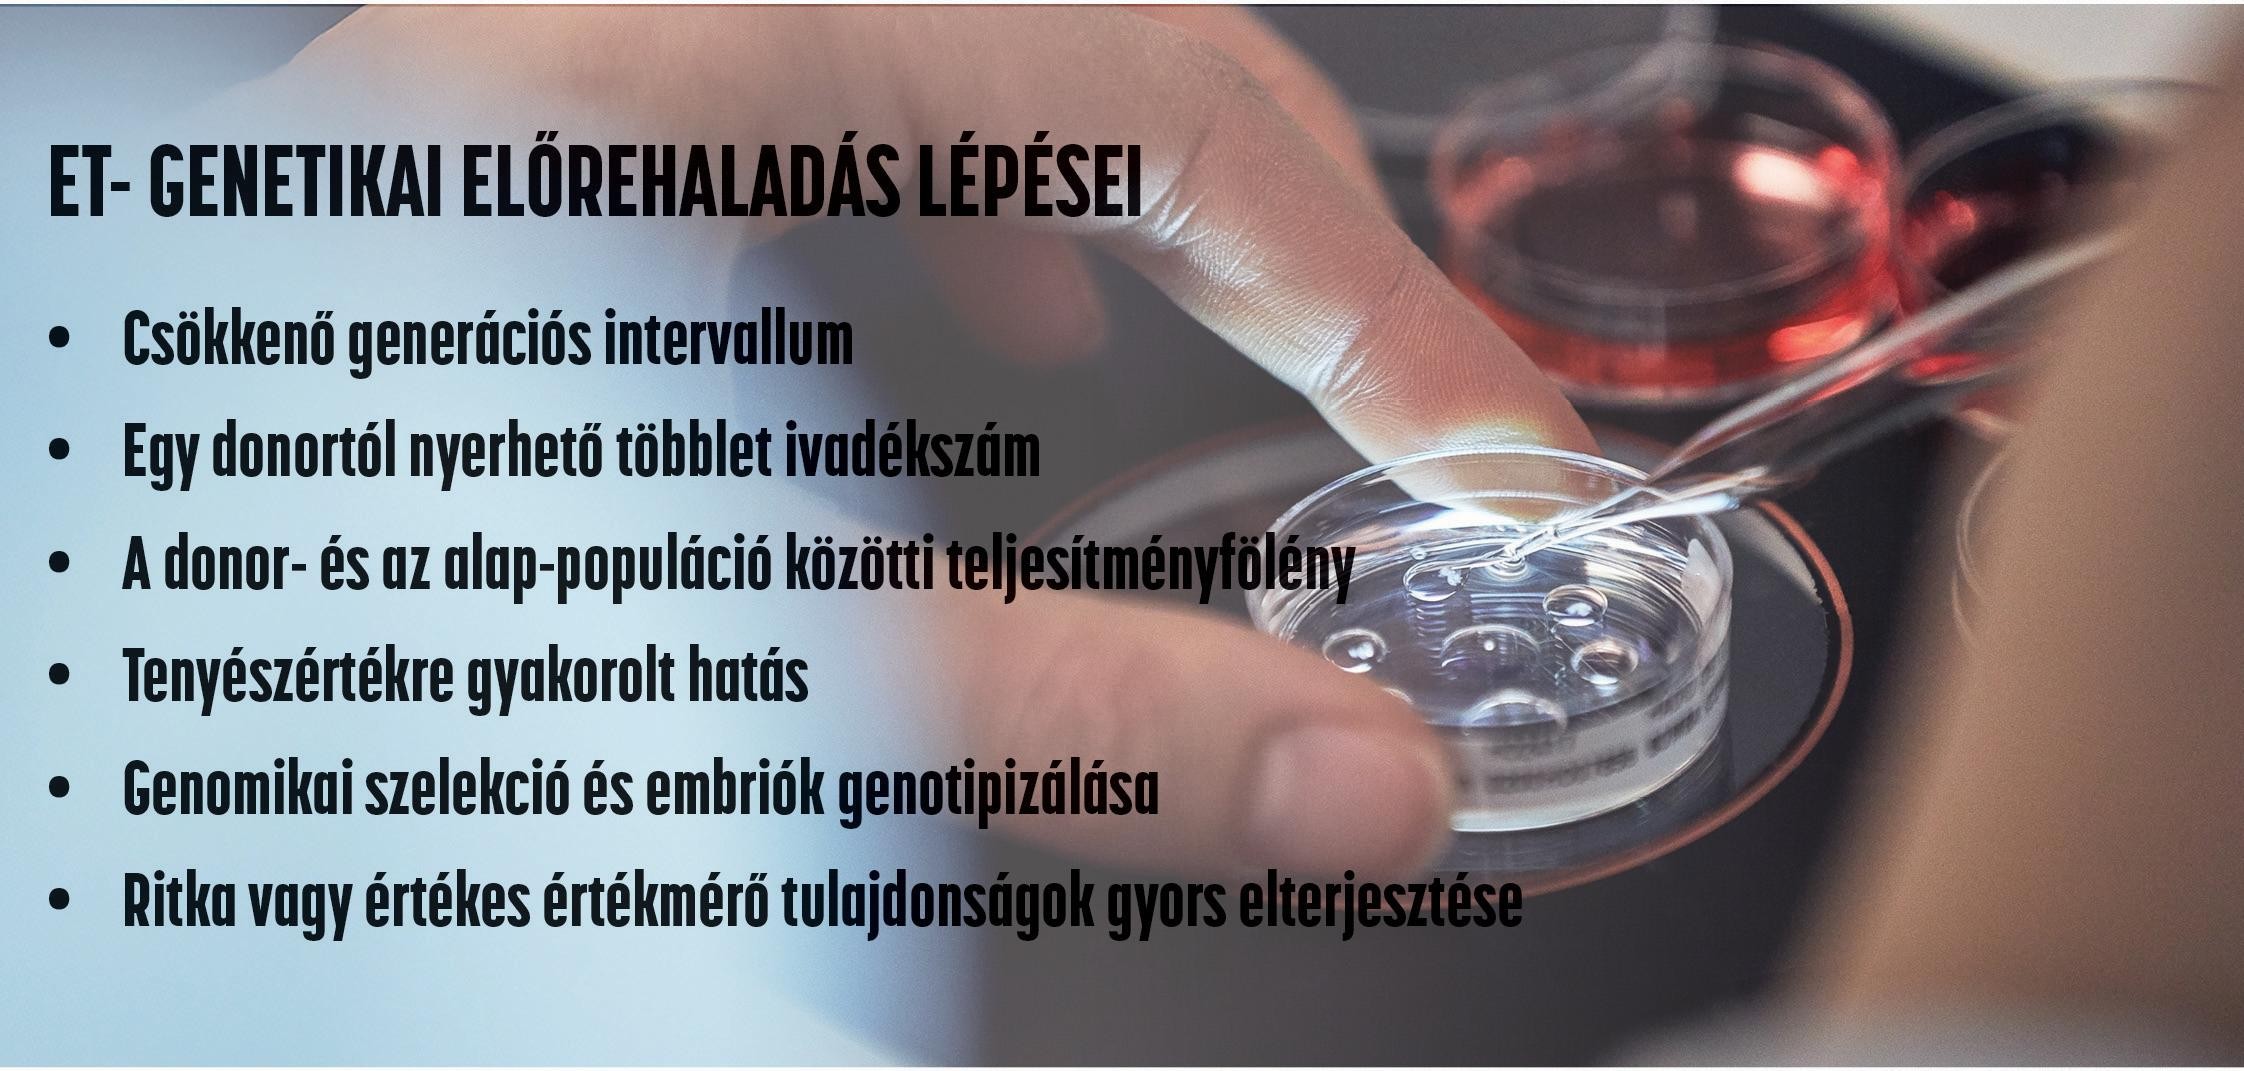

Március 7. Tamás névnapja van
5820 Mezőhegyes, Külterület 0646/15 hrsz. Tel.: +36 68 566-200 & Mobil: +36 30/337-7650 info@semex.hu

A tejtermelő ágazat számos globális kihívással néz szembe. Ilyen a precíziós állattenyésztés terjedése, amely alkalmazkodóképességet és tanulékonyságot vár el gazdasági haszonállatainktól. További fontos társadalmi igény a környezetvédelem, az üvegházhatású gázok (ÜHG) kibocsátásának a csökkentése, valamint az állatjólléti szempontok mind erőteljesebb érvényesítése az állati termék előállítása során. Nem hagyhatjuk figyelmen kívül a klímaváltozás okozta kihívásokat sem, amely az eddig alkalmazott takarmánynövénytermesztési technológia (őszi vetésű szálas tömegtakarmányok arányának növelése a tejtermelő állományok takarmányozásában) és istállóépítési koncepciók (hatékonyabb klímatechnológia) felülvizsgálatát is indukálhatja a közeljövőben. Ezekre a kihívásokra olyan tenyésztési megoldások szükségesek, melyek nemcsak a túléléshez, hanem a fejlődéshez is hozzájárulnak.

A tejtermelő ágazatot alapjaiban érintő globális kihívások mellett a hazai szereplőknek meg kellett küzdenie az egyik legsúlyosabb a fertőző betegséggel, a ragadós száj- és körömfájással (RSzKF) és az ezzel záró állományfelszámolásokkal. Az állatok leölésével az anyagi veszteség mellett a biológiai alapokat is felfoghatatlan mértékű kár érte. Tenyésztőgenerációk több évtizedes szakmai erőfeszítései váltak egyik pillanatról a másikra semmivé. A fertőzéssel érintett gazdaságok tejtermelése kiesett, jelentős gazdasági veszteségek jelentkeznek, a piaci és a fogyasztói bizalom is megrendül. A helyzet mielőbbi normalizálása, a kiesett állomány újratelepítése, a genetikai színvonal megtartása vagy további javítása sürgető feladat. Az újratelepítés sürgető, de adódik a kérdés, hogy milyen állománnyal? A magas genetikai értékű tenyészállatok (vemhes üsző, szűz üsző) nagy volumenű beszerzése gyakorlati kérdéseket vet fel; van e lehetőség több ezer nőivarú tenyészállat hazai beszerzésére, amellett, hogy biztosítanunk kell az elvárt, magas szintű állategészségügyi státuszt. A szarvasmarha faj hosszú generációs intervallumából (4-5 év) adódóan a gyors genetikai helyreállítást az időigényes hagyományos tenyésztés nem segíti. Emellett nem elhanyagolható a gazdasági kényszer sem, amely a tejtermelés mielőbbi újraindítását követeli meg a szakemberektől. Ilyen szakmai és közgazdasági követelményeket mérlegelve kell a legmegfelelőbb szakmai döntést meghozni, amely minden valószínűség szerint a kiváló tenyészértékű tenyészállatok és embriók együttes beszerzése lesz.
Az embriótranszfer (ET) hatékony választ kínál az előbb részletezett kihívásokra, előnyei több szinten is érvényesülnek. Gyors állománybővítést tesz lehetővé genetikailag értékes egyedekkel, különösen fagyasztott embriók esetén biztosítja a fertőzésmentes szaporítóanyag használatát. A kiváló genetikai értékű embriók a világ bármely tájáról beszerezhetők, az élőállat logisztikájánál alacsonyabb költséggel, állategészségügyi kockázat nélkül. Tehát, az IVP embriók a genetikai színvonal ugrásszerű emelésére is lehetőséget kínálnak. Az embriótranszfer alkalmazása esetén a fiatal üszők (11–13 hónap) donorként történő felhasználásával a generációs intervallum 22-23 hónapra rövidíthető, továbbá egy donor több embriót adhat, így genetikai hatása többszöröződik. A donorok kiválasztása genomikus tenyészérték és küllemi szempontok alapján történik, így a legjobb tulajdonságok célzottan örökíthetők. Biopsziás embriók genomikai genotipizálása lehetővé teszi a születés előtti szelekciót ivar, genotípus, vagy specifikus marker alapján (pl. A2A2, kappa-kazein, Red Carrier, stb.). További előnye, hogy a recipiensek 100%-ban üszőket fognak elleni, mely tovább növeli az eljárás hatékonyságát az állomány újjáépítése során.

A technológia segítségével egy, de akár két generációt „ugorhat” a tenyésztő, melynek eredménye egy kivételes tulajdonságokkal bíró csoport, az úgynevezett nukleusz állomány. E kivételes genetikai superior képességekkel rendelkező csoport az alapja a helyben végzett OPU-IVF programoknak, mely során akár 2 hetente, a donorok 7 hónapos korától 6-8 életképes embriót lehet nyerni.
E nagy mennyiségű csúcsgenetikát képviselő IVF embriót frissen, illetve később fagyasztva, a megfelelően kiválasztott recipiensekbe beültetve jelentős genetikai előrehaladást lehet elérni.
A precíziós állattenyésztés egyik rendkívül fontos eleme a genomikai tenyészérték. A közelmúltig a genetikai előrehaladás szinte kizárólagos eszköze a bikák szaporítóanyagának megfelelő használata (célpárosítás) volt. A genomika talán legfontosabb, új horizontokat mutató eredménye a nőivar ugyanolyan megbízhatóságú tenyészértékei, mint a bikák esetén.
Ezzel a nőivar is belépett a genetikai előrehaladás gyorsulását előidéző tényezők közé.
A genomikai tesztek felhőalapú szoftver segítségével könnyen és papírmentesen elvégezhetőek. A magas megbízhatóságú genomikai adatok a teljes nőivar számára rendelkezésre állnak, így a jövő tejelő állományának tervezése soha nem látott pontossággal történhet- számítógépes stratégiai tervezéssel, majd célpárosítással.
A genomikai tesztekkel ma megállapíthatjuk egy állomány metánkibocsátását (genetikai audit) és a fent leírt innovációk segítségével már egy generáció alatt is csökkenthető egy állomány ÜHG kibocsátása.
A precíziós tenyésztés lehetőséget ad egy állomány immunválaszának erősítésére genetika segítségével: az erősebb immunválasszal bíró állatok föcsteje sokkal több ellenanyagot tartalmaz, az ilyen állatok jobban reagálnak a vakcinákra és jóval alacsonyabb a betegségek előfordulása, akár 30 százalékkal is. Az ilyen precíziós tenyésztéssel létrehozott tenyészet egészségesebb, versenyképesebb tejet termel, ráadásul gazdaságosabban.
Összefoglalva, tehát az embriótranszfer alkalmazása az járvánnyal sújtott tejtermelő gazdaságok újrakezdésében és genetikai fejlesztésében nem csupán lehetőség, hanem stratégiai szükségszerűség is. A jelenlegi kihívások közepette olyan technológiai megoldásokat kell alkalmazni, amelyek képesek egyszerre biztosítani a fertőzésmentes újratelepítést, a gyors genetikai előrehaladást és a piaci versenyképesség megőrzését. A precíziós állattenyésztés és a biotechnológiai innovációk – különösen az OPU-IVF technológia – beépítése a hazai tenyésztői gyakorlatba lehetőséget teremt a XXI. századi tejtermelés megújítására és a globális szintű fenntarthatósági és genetikai elvárások teljesítésére.
HÚTH Balázs1 – VERES Zoltán2
1Széchenyi István Egyetem Albert Kázmér Mosonmagyaróvári Kar Állattudományi Tanszék
2Génbank-Semex Magyarország Kft., Mezőhegyes
Forrás: megjelent az Agrárágazat augusztusi számában